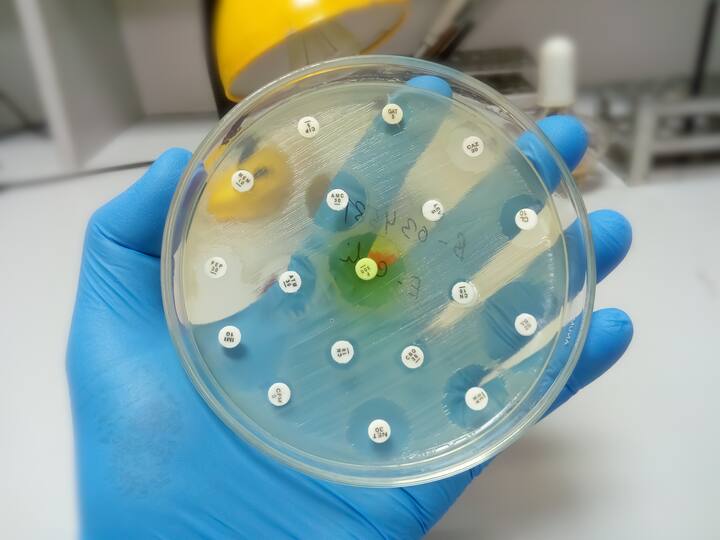

Rapid resistance testing services
Multi drug-resistant pathogens
We specialise in the detection of multi-drug-resistant pathogens, including Stenotrophomonas maltophilia and Acinetobacter spp., using advanced analytical methods. Our laboratory offers accurate results within two working days, utilising membrane filtration and validated chromogenic media, in line with international standards. We also provide antimicrobial resistance (AMR) testing for various pathogens.
Why choose Normec?
Accurate results for multi-drug-resistant pathogens within two working days, depending on organism growth times
Our methods combine membrane filtration and validated chromogenic media aligned with international standards
We offer antimicrobial resistance testing for a wide range of pathogens, using EUCAST guidelines
We provide bespoke testing solutions for complex or unusual cases where standard chromogenic media is unavailable
Fast detection of multi-drug-resistant bacteria
Multi-drug-resistant pathogens pose a serious risk in healthcare environments, where vulnerable patients are more susceptible to infections that don’t respond to standard treatments. Early and accurate detection is essential to prevent outbreaks, guide treatment plans and meet infection control standards.
This service gives healthcare providers fast, reliable insight into the presence of resistant bacteria. With tailored testing options and a turnaround of just two working days, teams can act quickly to safeguard patients and comply with regulatory expectations.
Detection of multi-drug-resistant pathogens
Stenotrophomonas maltophilia and Acinetobacter spp. are potentially life-threatening pathogens, particularly in healthcare settings. They are often resistant to many antibiotics and can be found in soil, water and in the hospital environment.
We’ve developed analytical methodologies to identify these bacteria. Our method is based on membrane filtration, combining procedures from the Standing Committee of Analysts and international standards with a validated chromogenic medium specific to this species of bacteria.
Antimicrobial resistance (AMR) testing
With increasing importance placed on antimicrobial resistance, as well as the World Health Organisation’s crisis action plan, we have developed analytical methodologies to identify resistant bacteria within the laboratory, with results provided in as little as 2 working days, dependent on organism growth times.
We have various methods based on membrane filtration, combining procedures from the Standing Committee of Analysts and international standards with fully validated media.
Determinant examples include:
CRE (Carbapenemase-resistant Enterobacteriaceae)
MRSA (Methicillin-resistant Staphylococcus aureus)
ESBL (Extended-spectrum beta-lactamase-producing bacteria)
VRE (Vancomycin-resistant enterococci)
In addition to the above, a number of more bespoke tests are available for the unique scenarios that you may encounter. If chromogenic media is not available for this test, we have capabilities to conduct antimicrobial sensitivities for all Cat 1 & 2 culturable bacteria using EUCAST guidelines.
Accreditations & Recognitions
We go for quality. For guaranteed results.
At Normec Latis Scientific, we uphold the highest standards of quality, safety, and environmental responsibility. We are certified for: - ISO 9001 – Quality Management Systems - ISO 14001 – Environmental Management Systems - ISO 45001 – Occupational Health and Safety Management Systems These certifications demonstrate our commitment to delivering reliable, safe, and sustainable services, while continuously improving our processes and protecting people and the environment. Proficiency Testing Proficiency testing is central to our quality system and provides confidence that our methods, equipment and staff are delivering the levels of quality required by UKAS and our clients. Normec Latis Scientific participates in external proficiency testing schemes provided by Public Health England and FAPAS.
UKAS schedule of accreditation
Our laboratories are accredited by the United Kingdom Accreditation Service (UKAS) to the norm ISO/IEC 17025:2017, the British, European and International Standard for quality assurance in analytical laboratories. The full standard covers quality assurance and method specific procedures, with all individual methods inspected and approved by UKAS. Normec Latis Scientific Limited, a UKAS accredited testing laboratory No. 2279.
Legionella Control Association
Latis Scientific hold the LCA Certificate of Registration issued by the Legionella Control Association (LCA).
These services might also be of interest to you

Comprehensive trade effluent testing

Validation services for product claims
Leading companies in this service

Normec Latis Scientific
London United Kingdom